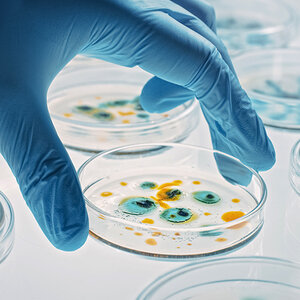
A closeup image of a scientist's hand holding a petri dish containig microbes. A closeup image of a scientist's hand holding a petri dish containig microbes.

Gates Foundation awards $1.5 million for precision antimicrobials
Seattle-based Phase Genomics, a for-profit life sciences company, has announced a $1.5 million grant from the Bill & Melinda Gates Foundation to help develop a precision antimicrobial discovery platform.
A collaboration between Phase Genomics and Lumen Bioscience, the platform aims to address a growing global antibiotic resistance crisis as well as the challenge of reducing global greenhouse gas emissions by utilizing lysins—phage-derived proteins that selectively kill specific bacteria and archaea, sparing off-target healthy microbes that are often collateral damage in traditional, systemic antibiotic treatment. The year-long project will deploy Phase Genomics’ proprietary global phage atlas to develop antimicrobial agents that bypass resistance against Campylobacter infections and methanogenic archaea in ruminants that drive global methane emissions.
“Our work at the frontier of microbiome research has unlocked a wealth of new insights on phages, the viruses that infect bacteria. Now, with support from the Gates Foundation, we’re harnessing our global phage database with the goal of improving human and environmental health and providing a critical alternative to traditional antibiotics,” said Phase Genomics founder and CEO Ivan Liachko. “The need for breakthrough therapeutics to combat the growing [anti-microbial resistance (AMR)] crisis is urgent. We’ve built the right technology to identify and engineer lysin candidates primed to combat microbes both in environmental settings as well as emerging AMR biothreats and help overcome the industry-wide inertia facing novel antibiotic development.”
(Photo Credit: Getty Images/gorodenkoff)







